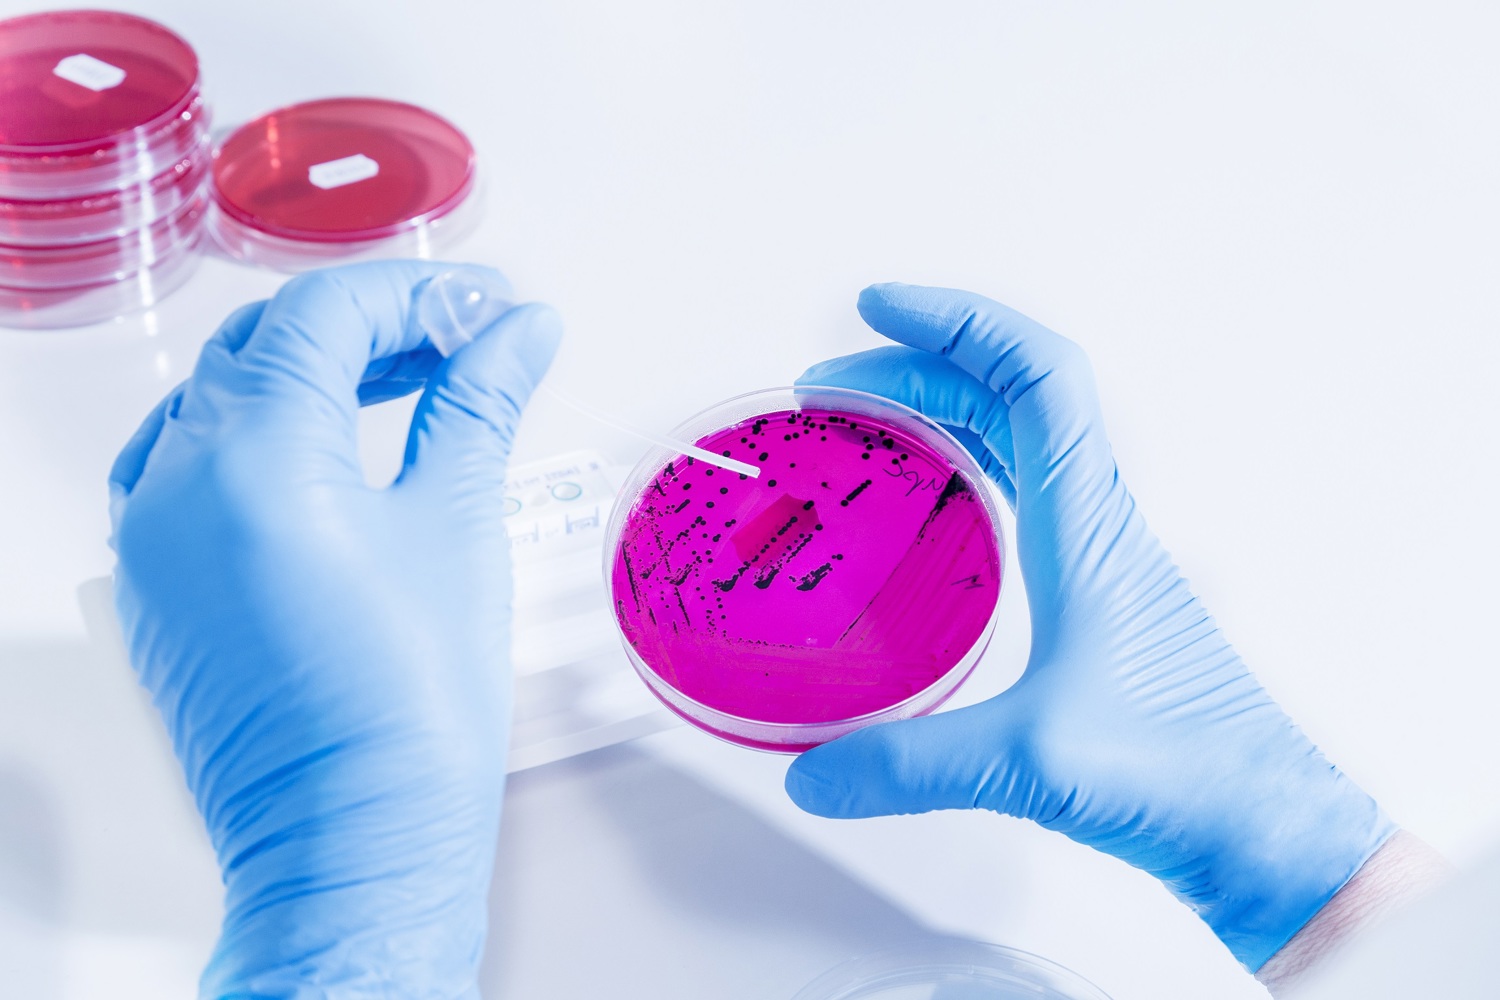

Feed Processing and Quality Programme
The overall goal of feed production is to achieve better nutrient utilisation and animal performance by optimising the use of raw materials and milling resources. Producing safe, nutritious, high-quality feed is top of mind for every feed processor.
Raw materials need to be safe to prevent transmission of harmful microbes from feed to the animal. And as more countries reduce antibiotic use in livestock production, there is a rising market demand for effective antimicrobial measures to prevent feed from being a source of contamination. This requires continuous monitoring and adaptive approaches – and demands both flexibility and innovation from feed producers. The challenge is how to balance feed quality with production costs and the increasing scarcity of raw materials.

We provide solutions for:
- Process moisture management: reducing the surface tension of water, managing moisture loss, and promoting deeper penetration of moisture and better pellet quality.
- Milling efficiency and processing optimisation: supporting better starch gelatinisation, increasing throughput, decreasing energy use and improving production parameters.
- Feed hygiene and shelf-life extension: Providing mould control, prolonging the efficacy of treatment products, and preventing and eliminating microbial (re-)contamination.
- Formaldehyde replacement: Using antimicrobial agents safely, extending efficacy, and preventing the negative impact of formaldehyde on animal performance and operator's health and safety.
Process moisture management
It is critical to manage moisture content in feed production once the moisture lost during feed production leads to process losses, including inventory shrinkage, decreased pellet durability and reduced throughput. However, it is possible to compensate moisture losses during feed processing in order to achieve a uniform quality in your finished feed.
Simply adding water to the feed during processing may increase the moisture content but it poses a number of threats. It also raises water activity in the feed, meaning that more free water is available for microorganisms to grow and consume valuable nutrients. And when you have a mix of ingredients with different water activity in the feed, ingredients with high water activity will impact those with low water activity, as moisture balances throughout the feed, leading to potential changes in texture, durability and palatability.
And water activity is not the only aspect of moisture that must be managed. Surface tension is another important parameter that has a significant impact on how deeply water and organic acids can penetrate into the feed particles and how long their effectiveness will last.
Because water has a relatively high surface tension, it is difficult for feed particles to absorb it. Water also poses challenges in terms of dispersion and spreading because its droplet size is large. Applying Selko's moisture management agents to the water before mixing with the feed can be a first step in improving absorption. Selko's Fylax and Fysal products can reduce surface tension, creating smaller droplets that are more easily absorbed within the feed. And not only does this potent mixture of specific organic acids and moisture management agents create a more even spread of the liquid, it also facilitates the organic acids to penetrate deeper and more effectively reduce harmful microbes.

Surface tension explained
As surface particles of the liquid attract each other, a “film” is formed, which makes the droplet pull together. This effect creates the tension that allows insects to walk on water without sinking. And it is also the very property that creates a challenge for feed production because a high water tension can prevent the water droplets from penetrating into the feed particle.
When water stays on the outer layer of the particles, it can become a perfect environment for harmful microbes to grow. Therefore, we incorporate potent moisture management agents in the Selko products, that reduce surface tension and allow moisture to be absorbed into the particles effectively.
Milling efficiency and processing optimisation
Most feed processing facilities use heat treatment during conditioning. Conditioning helps to reduce harmful pathogens, such as Salmonella and E.coli, and causes starch to become flexible and gel-like. This is known as starch gelatinisation.
Water’s surface tension affects the thermal (heat) conductivity of feed particles during pre-conditioning. When its surface tension is high, it is not well absorbed into the feed. However, when its surface tension is decreased, its absorption, or 'wettability', into the feedstuffs can significantly improve, highly impacting the feed manufacturing process.
This has to do with the fact that heat has a high conductiblibly through water. As a result, when water penetrates more deeply into the feed particles, this also improves the heat transfer, making it easier to transport heat from steam deep inside the feed particles. This can help starch gelatinisation and reduce microbial growth. Selko's Fylax products have a proven heat-resistance and will remain stable at pelleting and extrusion temperatures, allowing them to remain active and prevent (re-)contamination with microbes after production.


Feed hygiene and shelf-life extension
Climate change and raw material availability and quality are constant challenges faced by feed producers when manufacturing highly nutritional feed quality and avoiding microbial decay by moulds during and after feed processing. Using mould inhibitors helps prevent (re-)contamination in the process.
To reduce mould contamination within feed processing, Selko developed its Fylax product line. Fylax contains validated blends of buffered and non-buffered organic acids, as well as moisture management agents that reduce feed mill energy consumption by optimising the mash softer as it is pressed through the ring die rollers. To prevent or combat bacterial contamination (for example, Salmonella), the Fysal product line can be applied.
Pellet feed lines have the perfect conditions for mould or bacteria proliferation, due to high moisture and temperature levels. Feed residues can accumulate in the hammer mill, mixer, conditioner, pellet press, cooler and bagging stations and can contain high levels of moulds, enterobacteria and mycotoxins. This challenge requires proactive solutions to maintain feed mill hygiene and efficiency.
Applying Fylax or Fysal on crushed corn and flushing the feed lines for a specific amount of time can significantly reduce mould and enterobacteria contamination, leading to improved feed mill hygiene and feed quality. And applying liquid Fylax products during mixing helps to prolong final feed shelf life, by enabling acids to penetrate more deeply within feed particles, so that they remain active in the feed for a significant time after production.
Formaldehyde replacement
The European Union banned formaldehyde as a feed hygiene enhancer in 2018, due to significant health concerns. Scientific research showed that formaldehyde is carcinogenic through inhalation and even lower local concentrations of the chemical can initiate carcinogenesis by producing DNA adducts.
Research also shows that formaldehyde can react with groups of amino acids, including lysine, resulting in lower availability of amino acids to the animal, and affecting animal performance. This type of reaction may explain why formaldehyde reduces the total amount of available lysine and alters protein utilisation, ultimately lowering growth rates. Studies done in various species suggest that formaldehyde affects growth performance through feed’s nutritive content as well as by affecting the microbial community within the feed.
Though formaldehyde use is still permitted in large areas of the world, leading feed and animal producing companies are looking at alternative strategies to improve worker safety and support animal performance. Selko offers an effective and easy-to-implement strategy though organic acid blends.
Selko's portfolio of potent organic acid blends, mixed with specific ingredients, offer distinct advantages over formaldehyde. Safety is always our top priority; in addition to the lower risks to human and animal health, data shows that Selko products improve feed shelf life and reduce microbial loads. Fylax Forte-HC liquid, for example, shows a triple efficacy over formaldehyde in shelf-life extension. This result is achieved due to the buffering capacity of the product, which ensures a longer efficacy against formaldehyde's volatile nature.

Fylax shows triple efficacy over formaldehyde
Mould development on day 13 after treatment with commercial inclusion rates (left: formaldehyde 3kg/t, right: Fylax Forte-HC liquid 5kg/t).